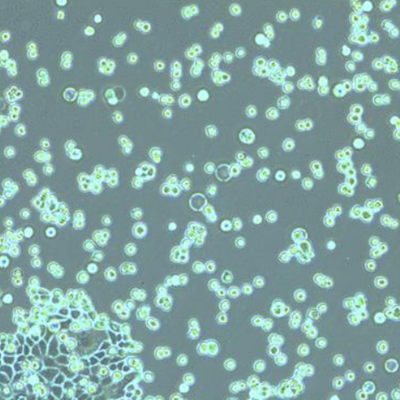

细胞培养
取您所需,利用徕卡显微系统的细胞和组织培养倒置显微镜提高活细胞成像工作流程中的效率。
这些使用简便的显微镜允许您根据自身需求配置相应的成像解决方案,可搭载灵活多样的聚光镜选件和数字成像记录功能,从未为您的实验室打造恰到好处的解决方案。
名称 | 形态学 | 来源 |
COS | 成纤维细胞样 | 非洲绿猴 |
HEK 293 | 上皮样 | 人类 |
CHO | 上皮样 | 仓鼠 |
MDCK | 上皮样 | 狗 |
HeLa 细胞 | 成纤维细胞样 | 人类 |
Jurkat | 淋巴母细胞样 | 人类 |
将细胞系用于细胞培养的一些实例。
显微镜 – 基本要求
我需要哪种工具?
为管理细胞培养实验室的日常工作,显微镜是一件必需品。此类显微镜必须具备倒置配置。倒置显微镜采用“物镜位于样品下方,聚光镜位于样品上方”的设计,这样就能使物镜尽量贴近细胞,并在上方保持较大的工作距离。
由于动物细胞的固有反差极低,细胞培养显微镜必须提供诸如相差等反差观察法。DIC (微分干涉相差) 在这里无法发挥作用,因为该技术无法配合塑料器皿用于细胞培养。DIC 有一个很好的替代方案,那就是 IMC (整合调制相差),该技术不仅能搭配塑料容器使用,而且无需借助专用物镜或棱镜。此外,细胞培养显微镜应易于操控,以避免浪费时间。
徕卡细胞培养显微镜具备出色的易用性,并可针对个性化需求提供灵活多样的反差观察方法。
显微镜 – 高级要求
我需要哪种工具?
一种很常见的细胞生物学科研手段是使用荧光标记转染细胞,以便使用研究型显微镜进行后续研究。如果您使用荧光蛋白,您的细胞培养显微镜还需要配备荧光选件,以用于控制转染效率。
为实现重要的记录和标准化目的,显微镜应配备数字摄像头,最好能够记录和梳理拍摄的数据。
由于细胞培养实验室都存在空间问题,细胞培养显微镜的尺寸不宜过大,例如,最好能安装在超净台中。此外,最新趋势都要求显微镜设计得足够小巧和稳固,以便在培养箱内部使用。
明场 | 相差 | 微分干涉相差 (DIC) | 整合调制相差 (IMC) | 荧光 | 放大倍率 | 工作距离 | 摄像头 | |
Leica DM IL LED | + | + | - | + | + | PH:5x 至 63x IMC:10x、20x、32x、40x | 40 mm、80 mm | + (自由选择) |
Leica DMi1 | + | + | - | - | - | 10x、20x、40x | 40 mm、50 mm、80 mm | + (集成式) |
Mateo TL | + | + | - | - | - | 4x, 10x, 20x, 40x | 50 mm | + (集成式) |
Mateo FL | + | + | - | - | + | 2.5x, 4x, 5x, 10x, 20x, 40x, 63x | 50 mm | + 双摄像头 (集成式) |
细胞培养实验室专用的显微镜。
用于大批量生产应用的显微镜
生产生物材料 (例如蛋白质、疫苗或抗体) 需要在大型器皿中培养细胞。
为应对这一要求,相关的细胞培养显微镜必须具备较大的工作距离和视场。此外,它需要具备极高的稳定性,以便牢固地承载大型器皿乃至大量器皿。
Leica DM IL LED 可使用超长透射光照明臂进行配置,以便您自由调节细胞培养器皿所需要的工作距离,高度最高可达 40 cm。
细胞检测
活细胞应用
细胞培养是一个动态过程。与其它任何生物系统一样,细胞的生长和行为有时难以预测。因此,长期监测比仅仅在单个时间点检查细胞培养过程更具优势。
而这正是显微镜能够一展所长的地方,您可将其放置在培养箱中,以便全天候不间断地监测细胞。例如,借助这一特性,您可随时随地检查细胞培养的汇合程度。